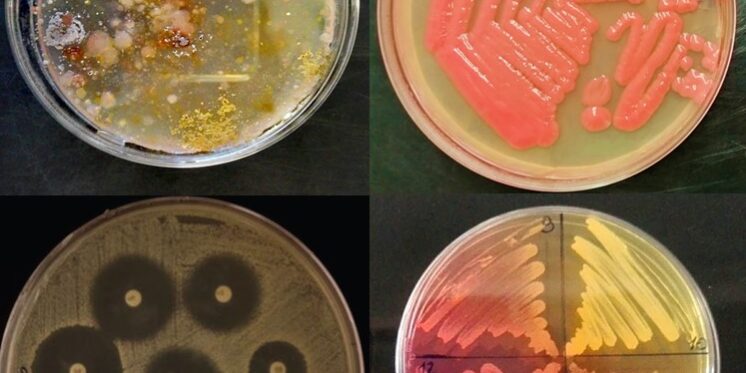

Microrganismi: alla scoperta del mondo invisibile
Tutto ciò che ci circonda è colonizzato da microrganismi, non solo gli ambienti, come suolo, acqua, superfici, ma anche la nostra pelle ed il nostro corpo. I batteri sono gli organismi più numerosi del pianeta, sebbene non riescano ad essere visibili ad occhio nudo per le loro dimensioni.
In questa occasione, sarà possibile osservare colonie di ceppi batterici, isolati da diversi ambienti, con differente morfologia e pigmentazione su terreni di coltura specifici.
In seguito al trattamento con lisozima, un enzima presente nelle secrezioni biologiche (come saliva e lacrime) saranno visualizzati al microscopio ottico i protoplasti, cellule batteriche private della parete cellulare, elemento essenziale per la vitalità dei batteri nell’ambiente.
Saranno mostrate colonie di ceppi batterici produttori di antibiotici o di particolari enzimi (come la catalasi) e il risultato di saggi di antibiotico-resistenza per mettere in evidenza le risposte dei batteri all’azione degli antibiotici.